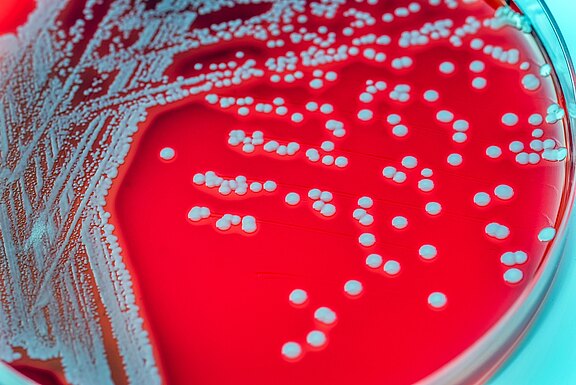
hygiene55.jpg

Untersuchung von Fleisch- & Lebensmittelproben
Die Qualität von Fleisch und Lebensmitteln kann durch Mikroorganismen oder Toxine massiv verändert werden. Deshalb ist es für die Herstellungsbetriebe von großer Wichtigkeit mikrobiologische Untersuchungen im Rahmen ihres HACCP-Konzeptes durchzuführen, die zum einen den Anforderungen der Gesetzgebung aber auch den wachsenden Qualitätsanforderungen der Verbraucher entsprechen.

Lebensmitteluntersuchungen im Rahmen der EG-Verordnung
Die Kommission der europäischen Gemeinschaft gibt zum Schutz der Gesundheit der Bevölkerung EG-Verordnungen heraus, in denen die Lebensmittelsicherheit durch Untersuchungsverfahren, Richt- und Grenzwerte festgelegt werden.
- Stanzproben + Gewebeproben
- Hackfleisch + Fleischzubereitung
- Abstrich-Untersuchungen
- Kratzschwamm-Methode auf Salmonellen
Fleisch & Lebensmittel
Weitergehend bieten wir mikrobiologische Untersuchungen von Lebensmitteln von folgenden Parametern an:
- Aerobe mesophile Gesamtkeimzahl
- Enterobacteriaceae
- E. coli
- Coliforme Keime
- Koagulase-positive Staphylokokken
- Pseudomonas spp.
- Enterococcus spp.
- mes. sulfitred. Clostridien
- Bacillus cereus
- Listeria monocytogenes, Keimzählverfahren
- Listeria spp. , Keimzählverfahren
- Listeria monocytogenes, Nachweisverfahren
- aerob wachsende Milchsäurebakterien
- Hefen- und Schimmelpilze
- Salmonellen
